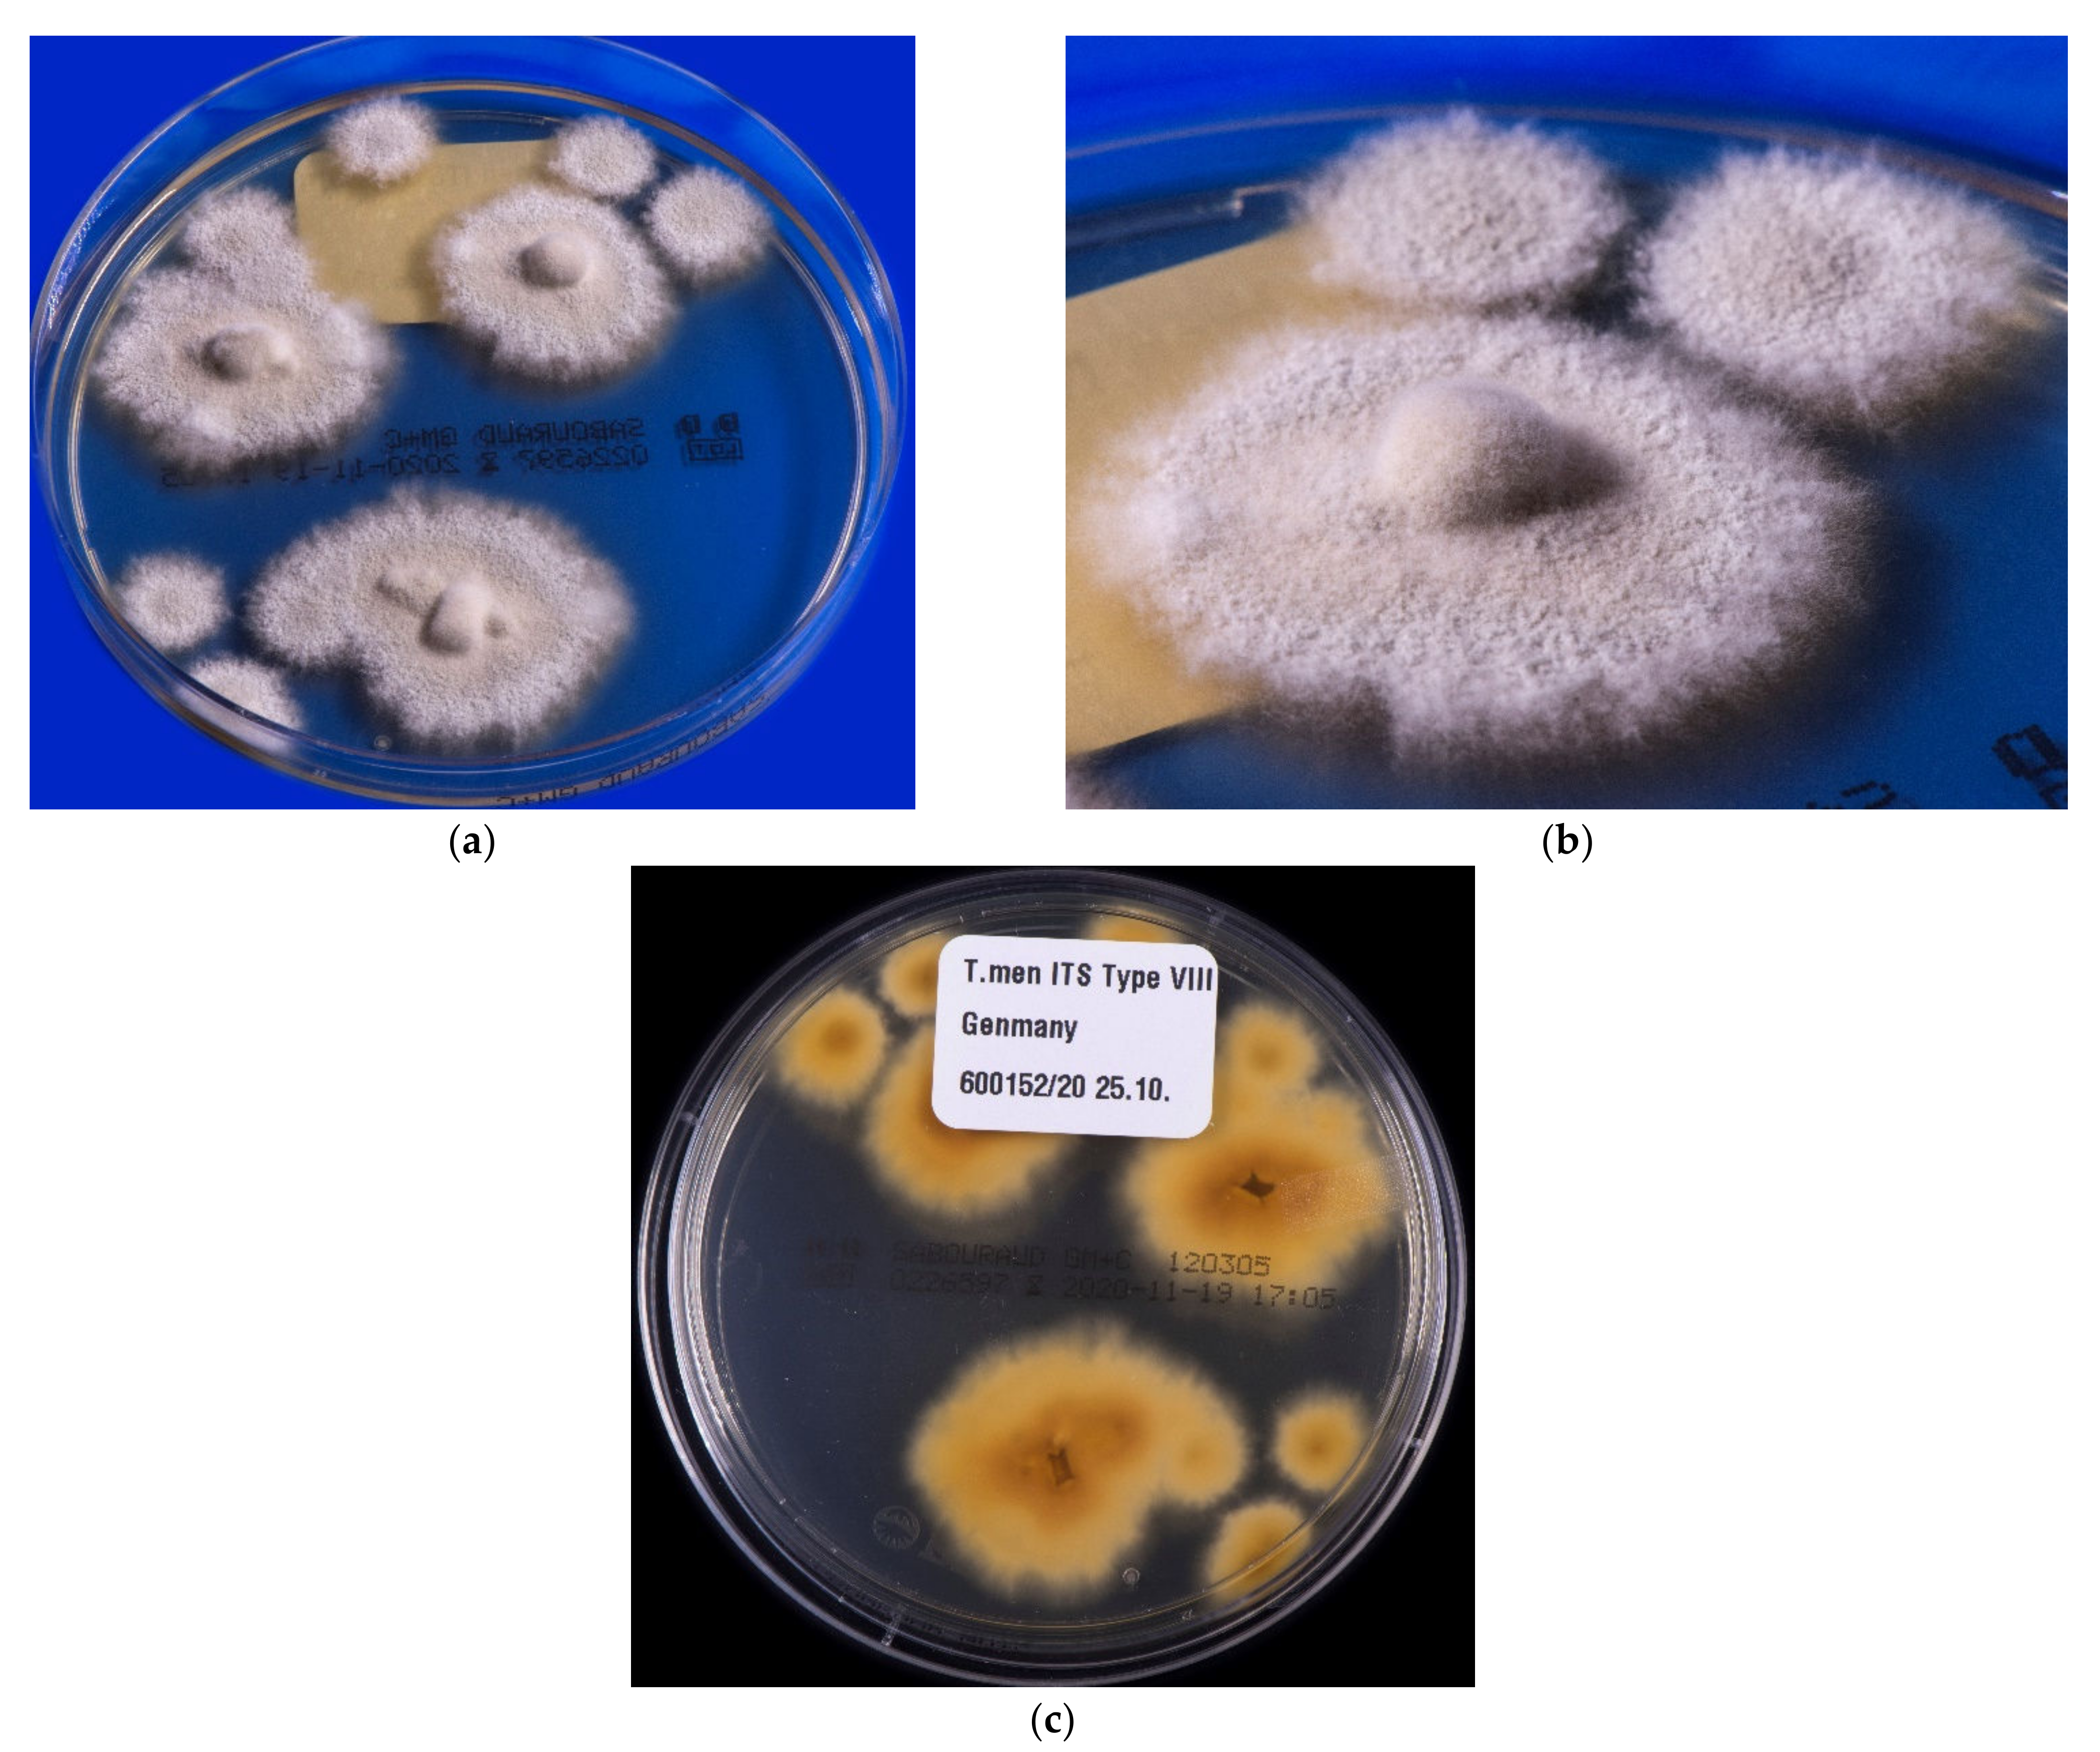
Jof 08 00757 g005

Trichophyton indotineae—An Emerging Pathogen Causing Recalcitrant Dermatophytoses in India and Worldwide—A Multidimensional Perspective
Abstract
:1. Introduction
2. Pathogen Change from Trichophyton rubrum to Trichophyton mentagrophytes
3. Trichophyton mentagrophytes Genotype VIII
4. Genotypes in the Trichophyton mentagrophytes/Trichophyton interdigitale Species Complex (TMTISC)
5. Trichophyton mentagrophytes Genotype VIII or Trichophyton indotineae?
6. Trichophyton indotineae—A New Dermatophyte Species
7. Sources of Infection and Routes of Transmission of Trichophyton indotineae
8. Terbinafine Resistance of Trichophyton indotineae
9. Abuse of Topical Glucocorticoids and the Emergence of Trichophyton indotineae
10. Treatment of Dermatophytoses Caused by Trichophyton indotineae
11. Conclusions
Author Contributions
Funding
Acknowledgments
Conflicts of Interest
References
- Seebacher, C.; Bouchara, J.-P.; Mignon, B. Updates on the epidemiology of dermatophyte infections. Mycopathologia 2008, 166, 335–352. [Google Scholar] [CrossRef] [Green Version]
- Nenoff, P.; Krüger, C.; Ginter-Hanselmayer, G.; Tietz, H.-J. Mycology—An update. Part 1: Dermatomycoses: Causative agents, epidemiology and pathogenesis. J. Dtsch. Dermatol. Ges. 2014, 12, 188–209. [Google Scholar] [CrossRef] [PubMed]
- Surendran, K.; Bhat, R.M.; Boloor, R.; Nandakishore, B.; Sukumar, D. A clinical and mycological study of dermatophytic infections. Indian J. Dermatol. 2014, 59, 262–267. [Google Scholar] [CrossRef] [PubMed]
- Verma, S.B. Comment on: Emergence of recalcitrant dermatophytosis in India. Lancet Infect. Dis. 2018, 18, 718–719. [Google Scholar] [CrossRef]
- Süß, A.; Uhrlaß, S.; Ludes, A.; Verma, S.B.; Monod, M.; Krüger, C.; Nenoff, P. Extensive tinea corporis due to a terbinafine-resistant Trichophyton mentagrophytes isolate of the Indian genotype in a young infant from Bahrain in Germany. Hautarzt 2019, 70, 888–896. [Google Scholar] [CrossRef]
- Fattahi, A.; Shirvani, F.; Ayatollahi, A.; Rezaei-Matehkolaei, A.; Badali, H.; Lotfali, E.; Ghasemi, R.; Pourpak, Z.; Firooz, A. Multidrug-resistant Trichophyton mentagrophytes genotype VIII in an Iranian family with generalized dermatophytosis: Report of four cases and review of literature. Int. J. Dermatol. 2021, 60, 686–692. [Google Scholar] [CrossRef]
- Nenoff, P.; Verma, S.B.; Ebert, A.; Süß, A.; Fischer, E.; Auerswald, E.; Dessoi, S.; Hofmann, W.; Schmidt, S.; Neubert, K.; et al. Spread of Terbinafine-Resistant Trichophyton mentagrophytes Type VIII (India) in Germany—“The Tip of the Iceberg?”. J. Fungi 2020, 6, 207. [Google Scholar] [CrossRef]
- Jabet, A.; Brun, S.; Normand, A.-C.; Imbert, S.; Akhoundi, M.; Dannaoui, E.; Audiffred, L.; Chasset, F.; Izri, A.; Laroche, L.; et al. Extensive dermatophytosis caused by Terbinafine-resistant Trichophyton indotineae, France. Emerg. Infect. Dis. 2022, 28, 229–233. [Google Scholar] [CrossRef]
- Dellière, S.; Joannard, B.; Benderdouche, M.; Mingui, A.; Gits-Muselli, M.; Hamane, S.; Alanio, A.; Petit, A.; Gabison, G.; Bagot, M.; et al. Emergence of difficult-to-treat tinea corporis caused by Trichophyton mentagrophytes complex isolates, Paris, France. Emerg. Infect. Dis. 2022, 28, 224–228. [Google Scholar] [CrossRef]
- Sacheli, R.; Hayette, M.-P. Antifungal resistance in dermatophytes: Genetic considerations, clinical presentations and alternative therapies. J. Fungi 2021, 7, 983. [Google Scholar] [CrossRef]
- Klinger, M.; Theiler, M.; Bosshard, P.P. Epidemiological and clinical aspects of Trichophyton mentagrophytes/Trichophyton interdigitale infections in the Zurich area: A retrospective study using genotyping. J. Eur. Acad. Dermatol. Venereol. 2021, 35, 1017–1025. [Google Scholar] [CrossRef]
- Siopi, M.; Efstathiou, I.; Theodoropoulos, K.; Pournaras, S.; Meletiadis, J. Molecular epidemiology and antifungal susceptibility of Trichophyton isolates in Greece: Emergence of Terbinafine-resistant Trichophyton mentagrophytes type VIII locally and globally. J. Fungi 2021, 7, 419. [Google Scholar] [CrossRef]
- Astvad, K.M.T.; Hare, R.K.; Jørgensen, K.M.; Saunte, D.M.L.; Thomsen, P.K.; Arendrup, M.C. Increasing terbinafine resistance in Danish Trichophyton isolates 2019–2020. J. Fungi 2022, 8, 150. [Google Scholar] [CrossRef]
- Kong, X.; Tang, C.; Singh, A.; Ahmed, S.A.; Al-Hatmi, A.M.S.; Chowdhary, A.; Nenoff, P.; Gräser, Y.; Hainsworth, S.; Zhan, P.; et al. Antifungal susceptibility and mutations in the squalene epoxidase gene in dermatophytes of the Trichophyton mentagrophytes species complex. Antimicrob. Agents Chemother. 2021, 65, e0005621. [Google Scholar] [CrossRef]
- Posso-De Los Rios, C.J.; Tadros, E.; Summerbell, R.C.; Scott, J.A. Terbinafine resistant Trichophyton indotineae isolated in patients with superficial dermatophyte infection in Canadian patients. J. Cutan. Med. Surg. 2022, 12034754221077891. [Google Scholar] [CrossRef]
- Ngo, T.M.C.; Ton Nu, P.A.; Le, C.C.; Ha, T.N.T.; Do, T.B.T.; Tran Thi, G. First detection of Trichophyton indotineae causing tinea corporis in Central Vietnam. Med. Mycol. Case Rep. 2022, 36, 37–41. [Google Scholar] [CrossRef]
- Saxena, V.; Shenoy, M.M.; Devrari, J.C.; Pai, V.; Agrawal, V. A mycological study of tinea corporis: A changing epidemiological trend from Trichophyton rubrum to Trichophyton mentagrophytes in India. Indian J. Dermatol. Venereol. Leprol. 2020, 86, 607. [Google Scholar] [CrossRef]
- Jain, S.; Kabi, S.; Swain, B. Current Trends of Dermatophytosis in Eastern Odisha. J. Lab. Physicians 2020, 12, 10–14. [Google Scholar] [CrossRef]
- Rajamohanan, R.; Raj, R.; Chellam, J.; Rengasamy, M. Epidemiological trends and clinicomycological profile of chronic dermatophytosis: A descriptive study from South India. Indian J. Dermatol. 2021, 66, 445. [Google Scholar] [CrossRef]
- Nenoff, P.; Verma, S.B.; Vasani, R.; Burmester, A.; Hipler, U.-C.; Wittig, F.; Krüger, C.; Nenoff, K.; Wiegand, C.; Saraswat, A.; et al. The current Indian epidemic of superficial dermatophytosis due to Trichophyton mentagrophytes—A molecular study. Mycoses 2019, 62, 336–356. [Google Scholar] [CrossRef]
- Seeliger, H.P.R.; Heymer, T. Diagnostik Pathogener Pilze des Menschen und Seiner Umwelt: Lehrbuch u. Atlas; Thieme: Stuttgart, Germany; New York, NY, USA, 1981; ISBN 3135953017. [Google Scholar]
- Gräser, Y.; Scott, J.; Summerbell, R. The new species concept in dermatophytes-a polyphasic approach. Mycopathologia 2008, 166, 239–256. [Google Scholar] [CrossRef] [Green Version]
- De Hoog, G.S.; Dukik, K.; Monod, M.; Packeu, A.; Stubbe, D.; Hendrickx, M.; Kupsch, C.; Stielow, J.B.; Freeke, J.; Göker, M.; et al. Toward a novel multilocus phylogenetic taxonomy for the dermatophytes. Mycopathologia 2017, 182, 5–31. [Google Scholar] [CrossRef] [Green Version]
- De Hoog, G.S.; Guarro, J.; Gené, J.; Ahmed, S.; Al-Hatmi, A.M.S.; Figueras, M.; Vitale, R.G. The ultimate benchtool für diagnosis. In Atlas of Clinical Fungi, version 1.4.1., 4th ed.; Centraalbureau Voor Schimmelcultures: Utrecht, The Netherlands; Universitat Rovira i Virgili: Reus, Spain, 1991; Available online: http://www.clinicalfungi.org/page/Atlas%20Online (accessed on 31 January 2021).
- Nenoff, P.; Krüger, C.; Schaller, J.; Ginter-Hanselmayer, G.; Schulte-Beerbühl, R.; Tietz, H.-J. Mycology—An update. Part 2: Dermatomycoses: Clinical picture and diagnostics. J. Dtsch. Dermatol. Ges. 2014, 12, 749–777. [Google Scholar] [CrossRef]
- Tamura, K.; Nei, M. Estimation of the number of nucleotide substitutions in the control region of mitochondrial DNA in humans and chimpanzees. Mol. Biol. Evol. 1993, 10, 512–526. [Google Scholar] [CrossRef]
- Heidemann, S.; Monod, M.; Gräser, Y. Signature polymorphisms in the internal transcribed spacer region relevant for the differentiation of zoophilic and anthropophilic strains of Trichophyton interdigitale and other species of T. mentagrophytes sensu lato. Br. J. Dermatol. 2010, 162, 282–295. [Google Scholar] [CrossRef]
- Taghipour, S.; Pchelin, I.M.; Zarei Mahmoudabadi, A.; Ansari, S.; Katiraee, F.; Rafiei, A.; Shokohi, T.; Abastabar, M.; Taraskina, A.E.; Kermani, F.; et al. Trichophyton mentagrophytes and T. interdigitale genotypes are associated with particular geographic areas and clinical manifestations. Mycoses 2019, 62, 1084–1091. [Google Scholar] [CrossRef]
- Kupsch, C.; Czaika, V.-A.; Deutsch, C.; Gräser, Y. Trichophyton mentagrophytes—A new genotype of zoophilic dermatophyte causes sexually transmitted infections. J. Dtsch. Dermatol. Ges. 2019, 17, 493–501. [Google Scholar] [CrossRef]
- Singh, A.; Masih, A.; Khurana, A.; Singh, P.K.; Gupta, M.; Hagen, F.; Meis, J.F.; Chowdhary, A. High terbinafine resistance in Trichophyton interdigitale isolates in Delhi, India harbouring mutations in the Squalene epoxidase (SQLE) gene. Mycoses 2018, 61, 477–484. [Google Scholar] [CrossRef]
- Nenoff, P.; Verma, S.B.; Uhrlaß, S.; Burmester, A.; Gräser, Y. A clarion call for preventing taxonomical errors of dermatophytes using the example of the novel Trichophyton mentagrophytes genotype VIII uniformly isolated in the Indian epidemic of superficial dermatophytosis. Mycoses 2019, 62, 6–10. [Google Scholar] [CrossRef] [PubMed] [Green Version]
- Nenoff, P.; Uhrlass, S.; Verma, S.B.; Panda, S. Trichophyton mentagrophytes ITS genotype VIII and Trichophyton indotineae: A terminological maze, or is it? Indian J. Dermatol. Venereol. Leprol. 2022. Online ahead of print. [Google Scholar]
- Verma, S.B.; Panda, S.; Nenoff, P.; Singal, A.; Rudramurthy, S.M.; Uhrlass, S.; Das, A.; Bisherwal, K.; Shaw, D.; Vasani, R. The unprecedented epidemic-like scenario of dermatophytosis in India: II. Diagnostic methods and taxonomical aspects. Indian J. Dermatol. Venereol. Leprol. 2021, 87, 326–332. [Google Scholar] [CrossRef] [PubMed]
- Kano, R.; Kimura, U.; Kakurai, M.; Hiruma, J.; Kamata, H.; Suga, Y.; Harada, K. Trichophyton indotineae sp. nov.: A new highly terbinafine-resistant anthropophilic dermatophyte species. Mycopathologia 2020, 185, 947–958. [Google Scholar] [CrossRef] [PubMed]
- Tang, C.; Kong, X.; Ahmed, S.A.; Thakur, R.; Chowdhary, A.; Nenoff, P.; Uhrlass, S.; Verma, S.B.; Meis, J.F.; Kandemir, H.; et al. Taxonomy of the Trichophyton mentagrophytes/T. interdigitale species complex harboring the highly virulent, multiresistant genotype T. indotineae. Mycopathologia 2021, 186, 315–326. [Google Scholar] [CrossRef] [PubMed]
- De Hoog, G.S.; Guarro, J.; Gené, J.; Ahmed, S.A.; Al-Hatmi, A.M.; Figueras, M.J.; Vitale, R.G. What is a Species Complex? Educational Atlas Clinical Fungi. Available online: https://www.clinicalfungi.org/page/Educational (accessed on 17 July 2022).
- Kawasaki, M.; Anzawa, K.; Wakasa, A.; Takeda, K.; Tanabe, H.; Mochizuki, T.; Ishizaki, H.; Hemashettar, B.M. Different genes can result in different phylogenetic relationships in Trichophyton species. Nihon Ishinkin Gakkai Zasshi 2008, 49, 311–318. [Google Scholar] [CrossRef]
- Kong, F.; Tong, Z.; Chen, X.; Sorrell, T.; Wang, B.; Wu, Q.; Ellis, D.; Chen, S. Rapid identification and differentiation of Trichophyton species, based on sequence polymorphisms of the ribosomal internal transcribed spacer regions, by rolling-circle amplification. J. Clin. Microbiol. 2008, 46, 1192–1199. [Google Scholar] [CrossRef] [Green Version]
- Verma, S.B.; Panda, S.; Nenoff, P.; Singal, A.; Rudramurthy, S.M.; Uhrlass, S.; Das, A.; Bisherwal, K.; Shaw, D.; Vasani, R. The unprecedented epidemic-like scenario of dermatophytosis in India: I. Epidemiology, risk factors and clinical features. Indian J. Dermatol. Venereol. Leprol. 2021, 87, 154–175. [Google Scholar] [CrossRef]
- Shen, J.J.; Arendrup, M.C.; Verma, S.; Saunte, D.M.L. The emerging terbinafine-resistant Trichophyton epidemic: What Is the role of antifungal susceptibility testing? Dermatology 2022, 238, 60–79. [Google Scholar] [CrossRef]
- Verma, S.B.; Panda, S.; Nenoff, P.; Singal, A.; Rudramurthy, S.M.; Uhrlass, S.; Das, A.; Bisherwal, K.; Shaw, D.; Vasani, R. The unprecedented epidemic-like scenario of dermatophytosis in India: III. Antifungal resistance and treatment options. Indian J. Dermatol. Venereol. Leprol. 2021, 87, 468–482. [Google Scholar] [CrossRef]
- Ebert, A.; Monod, M.; Salamin, K.; Burmester, A.; Uhrlaß, S.; Wiegand, C.; Hipler, U.-C.; Krüger, C.; Koch, D.; Wittig, F.; et al. Alarming India-wide phenomenon of antifungal resistance in dermatophytes: A multicentre study. Mycoses 2020, 63, 717–728. [Google Scholar] [CrossRef]
- Verma, S.B.; Vasani, R. Male genital dermatophytosis—Clinical features and the effects of the misuse of topical steroids and steroid combinations—An alarming problem in India. Mycoses 2016, 59, 606–614. [Google Scholar] [CrossRef]
- Verma, S.B.; Zouboulis, C. Indian irrational skin creams and steroid-modified dermatophytosis—An unholy nexus and alarming situation. J. Eur. Acad. Dermatol. Venereol. 2018, 62, 227. [Google Scholar] [CrossRef]
- Kothiwal, R.; Yadav, R.; Bohra, D.S.; Rawat, L.; Meherda, A.; Chawla, L.; Sharma, C. Trends of steroid modified tinea at tertiary care hospital in India. Int. Multispecialty J. Health 2017, 7, 263–267. [Google Scholar]
- Niedner, R. Klassifikation der Externkortikoide. ZFA 1983, 59, 367–369. [Google Scholar]
- Verma, S.B. Complex cost issues in treating dermatophytoses in India-“It all builds up”. Indian Dermatol. Online J. 2019, 10, 441–443. [Google Scholar] [CrossRef]
- Sheth, N.K.; Nair, P.A. Topical steroids: Awareness and misuse among patients, pharmacists and general medical practitioner. Indian J. Dermatol. Venereol. Leprol. 2021, 87, 54–59. [Google Scholar] [CrossRef]
- Chaudhary, R.G.; Rathod, S.P.; Jagati, A.; Baxi, K.; Ambasana, A.; Patel, D. Prescription and usage pattern of topical corticosteroids among out-patient attendees with dermatophyte infections and its analysis: A cross-sectional, survey-based study. Indian Dermatol. Online J. 2019, 10, 279–283. [Google Scholar] [CrossRef]
- Mahar, S.; Mahajan, K.; Agarwal, S.; Kar, H.K.; Bhattacharya, S.K. Topical corticosteroid misuse: The scenario in patients attending a tertiary care hospital in New Delhi. J. Clin. Diagn. Res. 2016, 10, FC16–FC20. [Google Scholar] [CrossRef]
- Thakran, P.; Agrawal, S.; Singal, A.; Verma, S.; Madhu, S.V. Iatrogenic Cushing’s syndrome in patients with superficial dermatophytosis. Indian Dermatol. Online J. 2021, 12, 237–243. [Google Scholar] [CrossRef]
- Singal, A.; Jakhar, D.; Kaur, I.; Pandhi, D.; Das, S. Tinea pseudoimbricata as a unique manifestation of steroid abuse: A clinico-mycological and dermoscopic study from a tertiary care hospital. Indian Dermatol. Online J. 2019, 10, 422–425. [Google Scholar] [CrossRef]
- Mason, D.; Marks, M. Bakua: Tinea imbricata in the solomon islands. Am. J. Trop. Med. Hyg. 2015, 92, 883. [Google Scholar] [CrossRef] [Green Version]
- Baah, N.; Levoska, M.A.; Randall, G.J.; Muakkassa, F.; Dawes, D.; Rothbaum, R.M. Concentric scaly rings in a patient with a history of breast cancer. JAAD Case Rep. 2020, 6, 503–505. [Google Scholar] [CrossRef] [PubMed]
- Lim, S.P.R.; Smith, A.G. “Tinea pseudoimbricata”: Tinea corporis in a renal transplant recipient mimicking the concentric rings of tinea imbricata. Clin. Exp. Dermatol. 2003, 28, 332–333. [Google Scholar] [CrossRef] [PubMed]
- Khurana, A.; Gupta, A.; Sardana, K.; Sethia, K.; Panesar, S.; Aggarwal, A.; Ghadlinge, M. A prospective study on patterns of topical steroids self-use in dermatophytoses and determinants predictive of cutaneous side effects. Dermatol. Ther. 2020, 33, e13633. [Google Scholar] [CrossRef] [PubMed]
- Thomas, M.; Wong, C.C.; Anderson, P.; Grills, N. Magnitude, characteristics and consequences of topical steroid misuse in rural North India: An observational study among dermatology outpatients. BMJ Open 2020, 10, e032829. [Google Scholar] [CrossRef]
- Verma, S.B.; Madke, B. Topical corticosteroid induced ulcerated striae. An. Bras. Dermatol. 2021, 96, 94–96. [Google Scholar] [CrossRef]
- Verma, S.B.; Madke, B.; Joshi, R.S.; Wollina, U. Pseudoedematous striae: An undescribed entity. Dermatol. Ther. 2020, 33, e13754. [Google Scholar] [CrossRef]
- Jha, K.; Shaw, D.; Karim, A.; Narang, T.; Saikia, B.; Rudramurthy, S.M.; Saikia, U.N.; Dogra, S. Immunological response and clinical profile in patients with recurrent dermatophytosis. Mycoses 2021, 64, 1429–1441. [Google Scholar] [CrossRef]
- Sardana, K.; Gupta, A.; Mathachan, S.R. Immunopathogenesis of Dermatophytoses and Factors Leading to Recalcitrant Infections. Indian Dermatol. Online J. 2021, 12, 389–399. [Google Scholar] [CrossRef]
- Burmester, A.; Hipler, U.-C.; Hensche, R.; Elsner, P.; Wiegand, C. Point mutations in the squalene epoxidase gene of Indian ITS genotype VIII T. mentagrophytes identified after DNA isolation from infected scales. Med. Mycol. Case Rep. 2019, 26, 23–24. [Google Scholar] [CrossRef]
- Gawaz, A.; Nenoff, P.; Uhrlaß, S.; Schaller, M. Treatment of a terbinafine-resistant Trichophyton mentagrophytes type VIII. Hautarzt 2021, 72, 900–904. [Google Scholar] [CrossRef]
- Singh, S.; Chandra, U.; Anchan, V.N.; Verma, P.; Tilak, R. Limited effectiveness of four oral antifungal drugs (fluconazole, griseofulvin, itraconazole and terbinafine) in the current epidemic of altered dermatophytosis in India: Results of a randomized pragmatic trial. Br. J. Dermatol. 2020, 183, 840–846. [Google Scholar] [CrossRef]
- Verma, S.B.; Madhu, R. The great Indian epidemic of superficial dermatophytosis: An appraisal. Indian J. Dermatol. 2017, 62, 227–236. [Google Scholar] [CrossRef]
- Brasch, J.; Gräser, Y.; Beck-Jendroscheck, V.; Voss, K.; Torz, K.; Walther, G.; Schwarz, T. “Indian” strains of Trichophyton mentagrophytes with reduced itraconazole susceptibility in Germany. J. Dtsch. Dermatol. Ges. 2021, 19, 1723–1727. [Google Scholar] [CrossRef]
- Zareshahrabadi, Z.; Totonchi, A.; Rezaei-Matehkolaei, A.; Ilkit, M.; Ghahartars, M.; Arastehfar, A.; Motamedi, M.; Nouraei, H.; Sharifi Lari, M.; Mohammadi, T.; et al. Molecular identification and antifungal susceptibility among clinical isolates of dermatophytes in Shiraz, Iran (2017–2019). Mycoses 2021, 64, 385–393. [Google Scholar] [CrossRef]
- Shaw, D.; Singh, S.; Dogra, S.; Jayaraman, J.; Bhat, R.; Panda, S.; Chakrabarti, A.; Anjum, N.; Chowdappa, A.; Nagamoti, M.; et al. MIC and upper limit of wild-type distribution for 13 antifungal agents against a Trichophyton mentagrophytes-Trichophyton interdigitale complex of indian origin. Antimicrob. Agents Chemother. 2020, 64, e01964-19. [Google Scholar] [CrossRef]

| Genotype | MK/MF | Genetic Origin | Type of Transmission | Type of Tinea | Geographical Assignment |
|---|---|---|---|---|---|
| Trichophyton interdigitale I | MK312693 OM951149 OM951137 MK447595 | Anthropophilic | Anthropophilic | Tinea pedis, Tinea unguium | Australia, Belgium, Finland, France, Germany, Iran, Portugal, Switzerland |
| Trichophyton interdigitale II | MK447596 MK312677 OM951151 OM951143 OM951146 | Anthropophilic | Anthropophilic | Tinea pedis, Tinea unguium | Austria, Australia, Belgium, Brazil, Canada, China, Croatia, Czech Republic, Egypt, Estonia, Finland, France, Gabon, Germany, India, Iran, Japan, Malaysia, Netherlands, Portugal, Russia, South Korea, Spain, Switzerland, Tunisia, United Kingdom, USA |
| Trichophyton interdigitale X | MK312735 | Anthropophilic | Anthropophilic | Tinea pedis | Iran |
| Trichophyton interdigitale XI | MK312755 | Anthropophilic | Anthropophilic | Tinea manuum | Iran |
| Trichophyton interdigitale XII | MK312683 | Anthropophilic | Anthropophilic | Tinea pedis | Iran |
| Trichophyton interdigitale/T. mentagrophytes II* Mixed type | MN886820 MN886818 MK313075 MK630684 MH708282 MT420725 | Anthropophilic/zoophilic | Zoophilic | Tinea corporis, tinea cruris, tinea faciei, tinea unguium | Australia, Belgium, Cambodia, China, France, Germany, Greece, India, Iran, Iraq, Israel, Japan, Netherlands, New Zealand, Russia, South Korea, Thailand, United Kingdom, Vietnam |
| Trichophyton mentagrophytes III | KJ606099 MK450325 OM951159 OM951152 OM951161 | Zoophilic | Zoophilic | Tinea corporis, tinea manuum | Estonia, Finland, France, Germany, Russia, Switzerland |
| Trichophyton mentagrophytes III* | MK312889 MK447605 | Zoophilic | Zoophilic | Tinea faciei, tinea inguinalis, tinea corporis, tinea genitalis, tinea manuum, tinea capitis, tinea pedis | Belgium, Canada, Czech Republic, Finland, France, Germany, Greece, India, Iran, Italy, Japan, Russia, Spain, Switzerland, United Kingdom |
| Trichophyton mentagrophytes IV | MK447609 | Zoophilic | Zoophilic | Tinea faciei, tinea inguinalis, tinea corporis, tinea genitalis, tinea manuum | France, Germany, Netherlands, South Africa, Switzerland, United Kingdom, USA |
| Trichophyton mentagrophytes V | MK312957 MT374268 MT374269 | Zoophilic | Zoophilic | Tinea corporis, tinea capitis | Egypt, Iran, Iraq, Spain, USA |
| Trichophyton mentagrophytes VI | MK722518 | Zoophilic | Zoophilic | Tinea faciei | Finland, Moldovia, Poland, Russia |
| Trichophyton mentagrophytes VII | MK447611 | Zoophilic | Anthropophilic | Tinea corporis, tinea genitalis, tinea faciei, tinea cruris, tinea capitis | Australia, Austria, France, Georgia, Germany, Oman, Russia, Switzerland, Thailand, USA, Vietnam |
| Trichophyton mentagrophytes VIII = Trichophyton indotineae | MH791418 OM951020 OM951135 OM951144 OM951139 OM951140 MT367568 MN661258 OM951136 OM951142 OM951134 OM951138 OM951141 OM951147 MN886817 MK313066 | Zoophilic | Anthropophilic | Tinea corporis, tinea cruris, tinea genitalis, tinea faciei, tinea inguinalis | Australia, Austria, Bahrain, Belgium, Cambodia, Canada, China, Denmark, Estonia, Finland, France, Germany, Greece, India, Iran, Iraq, Oman, Poland, Russia, Switzerland, UAE |
| Trichophyton mentagrophytes IX | MK447613 | Zoophilic | Zoophilic | Tinea corporis | Australia, Germany |
| Trichophyton mentagrophytes XIII | MK312917 | Anthropophilic | Zoophilic | Tinea corporis | Iran |
| Trichophyton mentagrophytes XIV | MK312950 | Anthropophilic | Zoophilic | Tinea faciei | Iran |
| Trichophyton mentagrophytes XV | MK312934 | Anthropophilic | Zoophilic | Tinea corporis, tinea faciei | Iran |
| Trichophyton mentagrophytes XVI | MK312933 | Anthropophilic | Zoophilic | Tinea corporis | Iran |
| Trichophyton mentagrophytes XVII | MK312976 | Anthropophilic | Zoophilic | Tinea corporis, tinea capitis, tinea cruris | Iran |
| Trichophyton mentagrophytes XVIII | MK313028 | Anthropophilic | Zoophilic | Tinea corporis | Iran |
| Trichophyton mentagrophytes XIX | MK312878 | Anthropophilic | Zoophilic | Tinea cruris | Iran |
| Trichophyton mentagrophytes XX | MK313030 | Anthropophilic | Zoophilic | Tinea manuum | Iran |
| Trichophyton mentagrophytes XXI | MK312887 | Anthropophilic | Zoophilic | Tinea corporis | Iran |
| Trichophyton mentagrophytes XXII | MK312888 | Anthropophilic | Zoophilic | Tinea corporis | Iran |
| Trichophyton mentagrophytes XXIII | MK313044 | Anthropophilic | Zoophilic | Tinea pedis | Iran |
| Trichophyton mentagrophytes XXIV | MK312924 | Anthropophilic | Zoophilic | Tinea manuum | Belgium, Brazil, Finland, France, Germany, Iran, Japan |
| Trichophyton mentagrophytes XXV | MN886815 MN886816 | Zoophilic | Zoophilic | Tinea corporis | Cambodia |
| Trichophyton mentagrophytes XXVI | OM951150 OM951153 OM951145 OM951148 OM951156 | Zoophilic | Zoophilic | Tinea corporis | Finland, Germany |
| Trichophyton mentagrophytes XXVII | OM951158 OM951160 | Zoophilic | Zoophilic | Tinea corporis | Germany |
| Trichophyton mentagrophytes XXVIII | OM951157 OM951162 | Zoophilic | Zoophilic | Tinea corporis | Germany |
| Trichophyton quinckeanum | KU257460 KU257461 KU257469 KY680503 | Zoophilic | Zoophilic | Tinea faciei, tinea corporis, tinea genitalis, tinea manuum, tinea capitis | Germany |
Publisher’s Note: MDPI stays neutral with regard to jurisdictional claims in published maps and institutional affiliations. |
© 2022 by the authors. Licensee MDPI, Basel, Switzerland. This article is an open access article distributed under the terms and conditions of the Creative Commons Attribution (CC BY) license (https://creativecommons.org/licenses/by/4.0/).
Share and Cite
Uhrlaß, S.; Verma, S.B.; Gräser, Y.; Rezaei-Matehkolaei, A.; Hatami, M.; Schaller, M.; Nenoff, P. Trichophyton indotineae—An Emerging Pathogen Causing Recalcitrant Dermatophytoses in India and Worldwide—A Multidimensional Perspective. J. Fungi 2022, 8, 757. https://doi.org/10.3390/jof8070757
Uhrlaß S, Verma SB, Gräser Y, Rezaei-Matehkolaei A, Hatami M, Schaller M, Nenoff P. Trichophyton indotineae—An Emerging Pathogen Causing Recalcitrant Dermatophytoses in India and Worldwide—A Multidimensional Perspective. Journal of Fungi. 2022; 8(7):757. https://doi.org/10.3390/jof8070757
Chicago/Turabian StyleUhrlaß, Silke, Shyam B. Verma, Yvonne Gräser, Ali Rezaei-Matehkolaei, Maryam Hatami, Martin Schaller, and Pietro Nenoff. 2022. "Trichophyton indotineae—An Emerging Pathogen Causing Recalcitrant Dermatophytoses in India and Worldwide—A Multidimensional Perspective" Journal of Fungi 8, no. 7: 757. https://doi.org/10.3390/jof8070757
APA StyleUhrlaß, S., Verma, S. B., Gräser, Y., Rezaei-Matehkolaei, A., Hatami, M., Schaller, M., & Nenoff, P. (2022). Trichophyton indotineae—An Emerging Pathogen Causing Recalcitrant Dermatophytoses in India and Worldwide—A Multidimensional Perspective. Journal of Fungi, 8(7), 757. https://doi.org/10.3390/jof8070757

